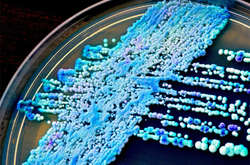
Дріжджові гриби виду Candida: багато видів цих грибів нешкідливі, проте деякі стають збудниками небезпечних недуг

Названо причину, через яку Україна очолила рейтинг країн із найвищим ризиком посухи (карта)

Рейтинг складали з урахуванням трьох показників – сільськогосподарського, промислового і регіонального
Інститут світових ресурсів опублікував перелік країн, яким загрожує посуха. Очолили його аж ніяк не африканські країни, що межують з Сахарою. На першому місці за кількістю ризиків опинилася Молдова, а от на друге місце потрапила Україна, повідомляє World Resources Institute. Загалом у списку WRI (World Resources Institute) – 138 держав. Їх розташували, проаналізувавши сільськогосподарські, промислові та регіональні показники.
Загалом у списку WRI (World Resources Institute) – 138 держав. Їх розташували, проаналізувавши сільськогосподарські, промислові та регіональні показники.
Україна і Молдова мають найвищий ризик посухи у світі серед 138 країн. Про це свідчать дані дослідження Інституту світових ресурсів.
Перша п'ятірка країн із відчутним рівнем загрози (з коефіцієнтом у 0,75 і вище) – це Молдова, Україна, Бангладеш, Індія й Сербія. Рейтинг складали з урахуванням трьох показників – сільськогосподарського, промислового і регіонального.
Рейтинг складали з урахуванням трьох показників – сільськогосподарського, промислового і регіонального.
Зокрема, фахівці аналізували інтенсивність минулої посухи, наявність дефіциту води, ураження від посухи, чисельність населення, обсяг посівів і поголів'я худоби.
Утім, варто зауважити, що багато країн Африки до рейтингу не потрапили через відсутність доступу до даних для аналізу.
Як повідомлялося раніше, Українців чекає аномальне літо. Екологи б’ють на сполох.

Коментарі — 0